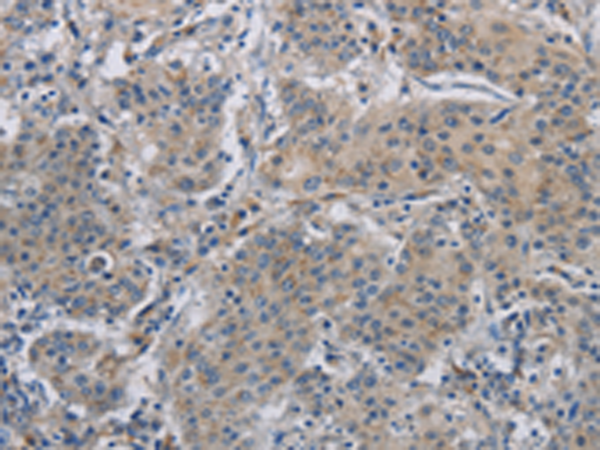

|
Background: |
DNAJB4 belongs to the evolutionarily conserved DNAJ/HSP40 protein family. For background information on the DNAJ family, see MIM 608375. |
|
Applications: |
ELISA, WB, IHC |
|
Name of antibody: |
DNAJB4 |
|
Immunogen: |
Fusion protein of human DNAJB4 |
|
Full name: |
DnaJ (Hsp40) homolog, subfamily B, member 4 |
|
Synonyms: |
DjB4; HLJ1; DNAJW |
|
SwissProt: |
Q9UDY4 |
|
ELISA Recommended dilution: |
2000-5000 |
|
IHC positive control: |
Human gastric cancer and human liver cancer |
|
IHC Recommend dilution: |
25-100 |
|
WB Predicted band size: |
38 kDa |
|
WB Positive control: |
Human fetal liver, mouse skeletal muscle and heart tissue, Hela and Jurkat cells |
|
WB Recommended dilution: |
500-2000 |
購物車
幫助
021-54845833/15800441009
